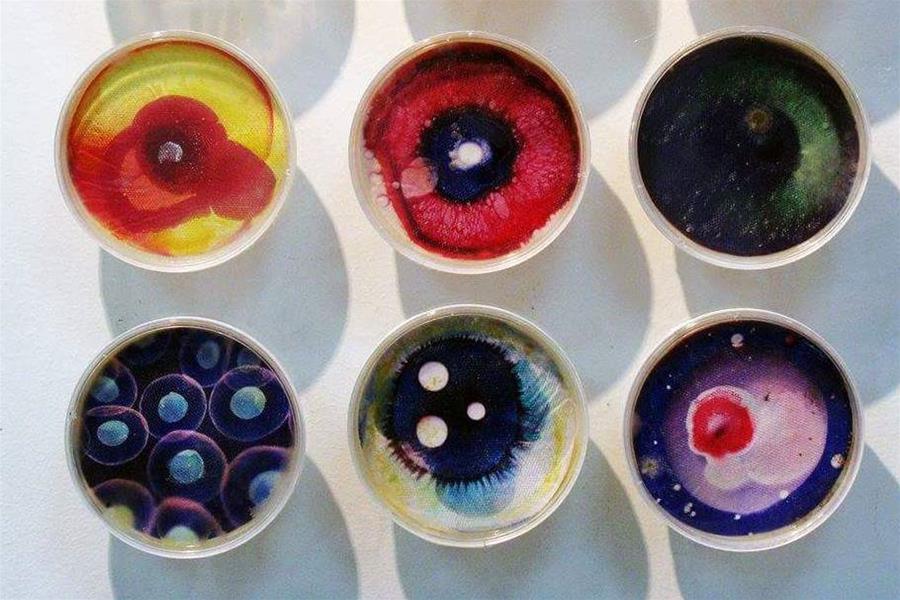

Glossaire des ARTS 

- B -
Bande Dessinée :
( N, f )Figuration narrativeLink
- Moyen d'expression Linkpopulaire très ancien apparu sous sa forme contemporaine au début du siècle aux Etats-Unis (comics) et qui s'est considérablement développé depuis la naissance de l'Ecole franco-belge vers les années 50.
- Forme de récit en images dessinées qui utilise des codes précis à l'intérieur desquelles peuvent figurer des sons (onomatopées), des commentaires, des dialogues qui s'inscrivent dans des 'bulles" (ballons ou phylactères).
Construite comme un film, la B.D. restitue l'illusion de la totalité de l'action en retenant les seuls temps forts et en décomposant le mouvement (Voir. narration).
voir: Glossaire de la BD
Baroque :
( N, m - Adj ) - style .
 Tendance artistique qui s'est développée du XVII ème siècle au XVIII ème siècle d'abord en Italie puis dans les pays catholiques d'Europe.
Tendance artistique qui s'est développée du XVII ème siècle au XVIII ème siècle d'abord en Italie puis dans les pays catholiques d'Europe.
A l'opposé du mouvement classique plus fidèle aux rythmes statiques, le mouvement baroque préfère les rythmes dynamiques et utilise surtout les courbes, le contraste lumineux, le trompe-l'œil et les effets de mouvement ainsi que de très nombreux ornements..png)
Le style baroque est décoratif et théâtral. Il a été répandu par l'église catholique pour attirer les fidèles au moment de la crise du protestantisme. (Le Bernin, Rubens).
Par extension, l’adjectif baroque (du portugais barocco, désignant une "perle irrégulière") signifie alambiqué, exagérément décoratif, bizarre.
C'est un style originaire d'Italie qui touche l'ensemble des disciplines artistiques (peinture, sculpture, architecture, musique...) mais également la littérature.
Le baroque désigne un art aux formes exubérantes, théâtrales et mouvementés contraire au bon goût classique. Ce mouvement artistique, issu de la Contre-Réforme, est au service de la foi catholique (donnant une imagerie vigoureuse, vivante et grandiose).
- Du portugais barocco, désignant une “perle irrégulière”. Le baroque désigne un art aux formes exubérantes, théâtrales et mouvementés contraire au bon goût classique. Mouvement artistique du 17e siècle, issu de la Contre-Réforme, au service de la foi catholique (image vigoureuse, vivante et grandiose).
BAUHAUS :
( nom propre ) - Terme allemand associant Bau (construction) et Haus (maison) qui désigne une Ecole d'art et d'architecture fondée en 1919 en Allemagne par l'architecte Walter Gropius, et fermée en 1933. Le rationalisme et le fonctionnalisme y servirent de principe aux arts appliqués.
L'enseignement visait à intégrer l'architecture à toutes les formes d'expression artistiques en favorisant des créations fonctionnelles et standardisées dans la société industrielle.
Ecole très influencée par l'abstraction géométrique, où enseignèrent notamment les peintres Paul KLEE, Wassily KANDINSKY, et Johannès ITTEN.
Bas relief :
( N,m )- Sculpture dont les formes se détachent légèrement de la surface du support, que ce soit en creux ou en épaisseur.
Le bas relief est différent de la ronde bosse qui est sculptée en trois dimensions.
Beau :
( Adj )Ce qui fait éprouver une émotion esthétique. "Les règles du beau sont éternelles, immuables et les formes en sont variables" (Delacroix) . Le beau est donc une notion qui peut varier selon les civilisations, les modes et les époques.
Bestiaire :
( N,m )Représentations d'animaux réels ou imaginaires dans une oeuvre ou un groupe d’oeuvres d'un même auteur ou d'une même époque. Les bestiaires étaient très courants au Moyen Age.
bidimentionnel :
( Adj )- Qui n'a que deux dimensions, largeur et hauteur ( ex: photo, dessin, peinture) , qui offre une surface plane.
Quand il y a trois dimensions, donc avec en plus une certaine épaisseur ou un certain volume, ( arts de l'espace : bas reliefs, sculpture, architecture, ) on dit 'tridimentionnel'.
Biennale :
( N,f )Manifestation culturelle , exposition d'oeuvres d'art qui a lieu en principe tous les deux ans à la même période.
ci -dessous les oeuvres d'art exposées lors de la biennale 2019 du Havre, qui ont pour certaines été conservées par la ville.
Binoculaire:
( Adj)La vision binoculaire est la vision humaine : avec les deux yeux (deux oculaires).
Certains tableaux utilisent la vision binoculaire pour donner la sensation de relief, deux tableaux presque similaires mais en fait d'un point de vue décalé correspondant à chaque œil sont vus en même temps. (Dali, voir images en relief).
voir aussi : stéréogramme
Bioart:
( n,m)La découverte et le développement des biotechnologies ont donné naissance au "Bio Art", domaine mêlant Art et Sciences : les perspectives de recherche offertes par ses nouvelles disciplines peuvent prendre plusieurs orientations : la culture de tissus vivants même quand il s’agit de la propre peau de l’artiste, les manipulations génétiques ou encore la biomécanique.
ex : Hubert Duprat, Marta de Menezes, Orlan , Oron Catts
Bitume:
( n,m)- Composé goudronneux de couleur marron foncé dont la difficulté à sécher occasionne de graves altérations de la couche picturale.
A la Renaissance, ce produit va faire son entrée dans les Beaux Arts en étant utilisé comme glacis final sur certains tableaux, notamment avec Léonard de Vinci sur sa « vierge aux rochers »
Le bitume, donc, quant à lui, d’origine minérale, ne sèche jamais tout à fait et donc ne donne pas aux couches de peinture une immobilité parfaite (sans parler des écarts de température qui peuvent rendre le bitume plus liquide).
Cette caractéristique sera fatale pour bon nombre de tableaux exécutés durant tout le 19ème siècle.
Avec l’avènement de la peinture romantique et son goût prononcé pour les ténèbres, les mystères, les forêts profondes etc… les peintres cherchent une couleur susceptible d’assombrir leur réalisation sans pour autant les « tuer » par une noirceur excessive que les noirs (noir de Mars, noir d’ivoire, noir de vignes) portent en eux. Le Bitume leur semble alors être la couleur rêvée pour parvenir à leur fin et ils vous donc en user plus que de raison dans les couches initiales qui rendront à terme pratiquement invisibles leurs tableaux quelques décennies plus tard.
Cette matière s’immisce dans les couleurs voisines, envahit l’ensemble des couches et le tableau se boursoufle, se craquelle et s'altère sans remède possible.
Body art :
( Adj)Art qui utilise comme support le corps humain.
biscuit :
( N,m)- En céramique, nom donné à une pièce de terre séchée et cuite une seule fois. Ensuite, pour l’émaillage, le biscuit est engobé (recouvert d’oxydes métalliques et de couverte) et cuit une seconde fois. (biscuit= bi cuit, cuit deux fois)
Blason :
( N, M )En héraldique, le blason est une description identifiant son porteur, pouvant être représentée sur un écu, une armure, une bannière ou un tabar. On parle également d'armes, les armoiries désignant l'écu et ses ornements extérieurs. Le blason est un signe de reconnaissance de l'individu ou de sa famille, particulièrement utilisé par les chevaliers au Moyen Âge. Néanmoins ce symbole ne leur est pas réservé : en France, il n'est pas besoin d'être issu de la noblesse pour créer son blason.
De nos jours, les régions, les villes voire leurs équipes de football ont parfois un blason .
Bord :
( N, f ) - Pourtour, partie située à la limite, au contour, ou encore à l’extrémité d’une surface ou d’un objet.
Brosse :
( N, f ) - Pinceau large et à bords droits ou légèrement arrondis, utilisé pour peindre les grandes surfaces car plus pratique qu'un pinceau fin.
Brut:
(Adj)
Tel quel, qui n’a pas subi d’intervention ou de transformation : un matériau brut.
Art brut:
( N,m )Désigne les œuvres d'artistes caractérisés par la spontanéité, l’inventivité et le « naturel », en dehors des codes convenus, sans avoir d'éducation artistique. L’Art brut est caractérisé par l’utilisation fréquente de matériaux a priori non artistiques ; il est proche de celui des marginaux, des productions des enfants avant l’apprentissage des codes de représentation (Chaissac, Dubuffet).
L'artiste havrais jean DUBUFFET revendiqua et opposa au monde de l'art et à son "asphyxiante culture" cette totale liberté et simplicité de création et contribua à la reconnaissance de ces artistes marginaux .
Burin:
( Adj,f )Outil de gravure servant à creuser le métal ou le bois.




.jpg)












.jpg)





.jpg)


.webp)

.%201972.jpg)
.jpg)
.jpg)












